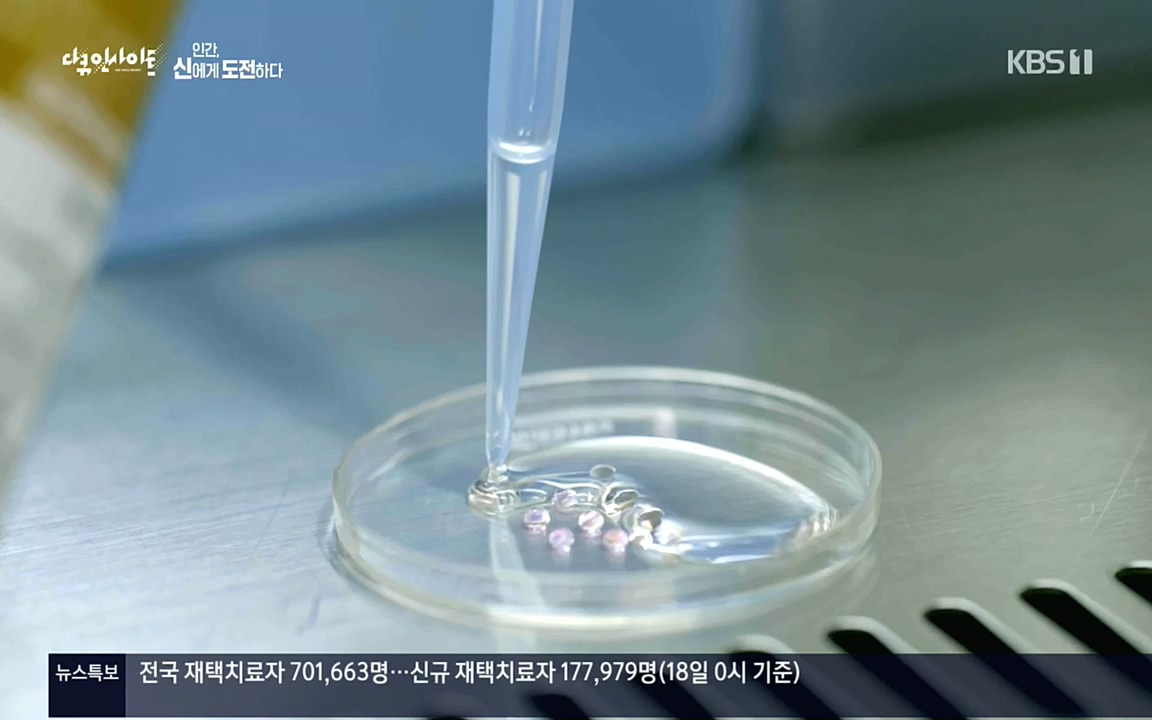

* 좋은 방송 잘봤습니다.

인간, 신에게 도전하다

홍원기
소아조로증
제 이름은 홍원기이고 소아조로증이라는 병이 있어요

Recurrent de novo point mutations in lamin A cause Hutchinson-Gilford progeria syndrome
Lamin A 돌연변이로 인한 프로게리아 증후군(조로증)의 발생 (미국 국립보건원, 2003)










홍원기
소아조로증
그럴 때마다 '아, 나한테 이 병이 있었지'




제 소망은 건강하게 스무 살, 서른 살에도 생일을 맞이하는 거예요


김진수 이학박사
학회 개최를 하루 이틀 앞두고 언론에서 실제 쌍둥이가 태어났다





















최초로 이 병을
극복한 사람이 되는 거예요














































나카무라 마사야 게이오 대학 의학부 교수
만성기라도 유도만능줄기세포를 이식하면 어느 정도의 기능 개선이 가능하고

댓글 없음:
댓글 쓰기